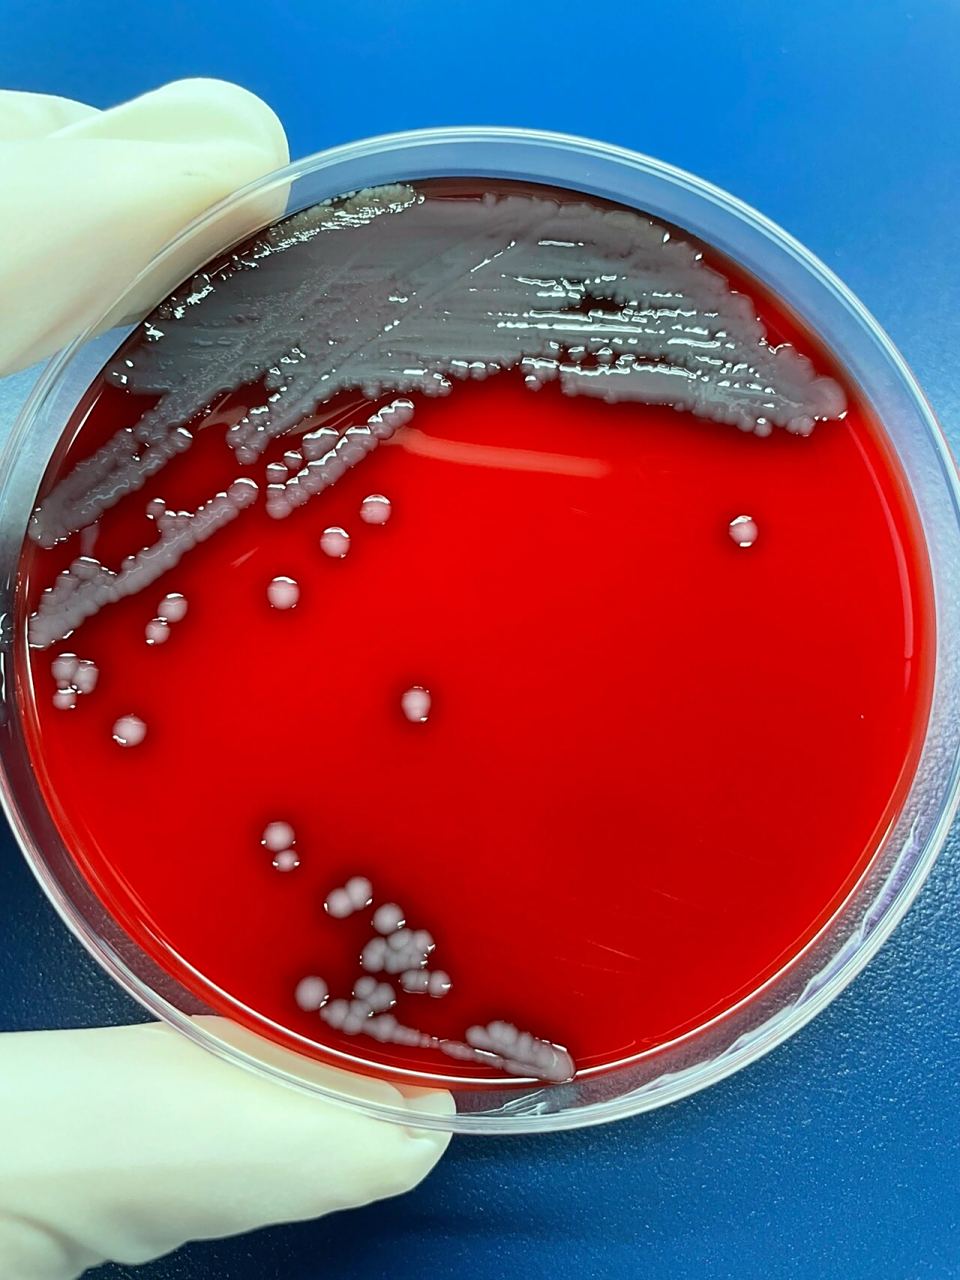
图1:tcbs平板上菌落形态 图23:血平板上菌落形态
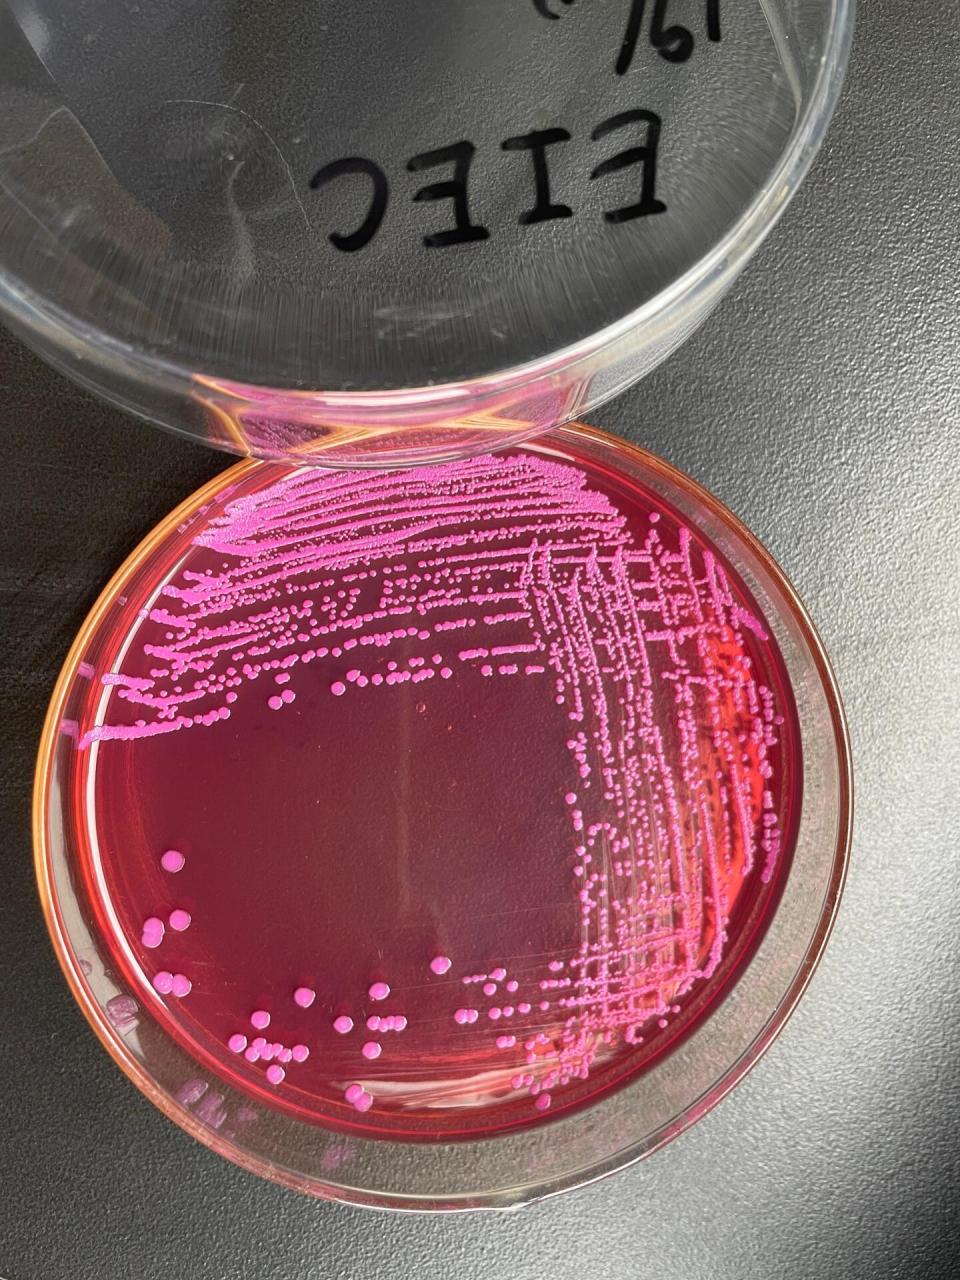
五种致泻性大肠杆菌在ss平板上的菌落形态
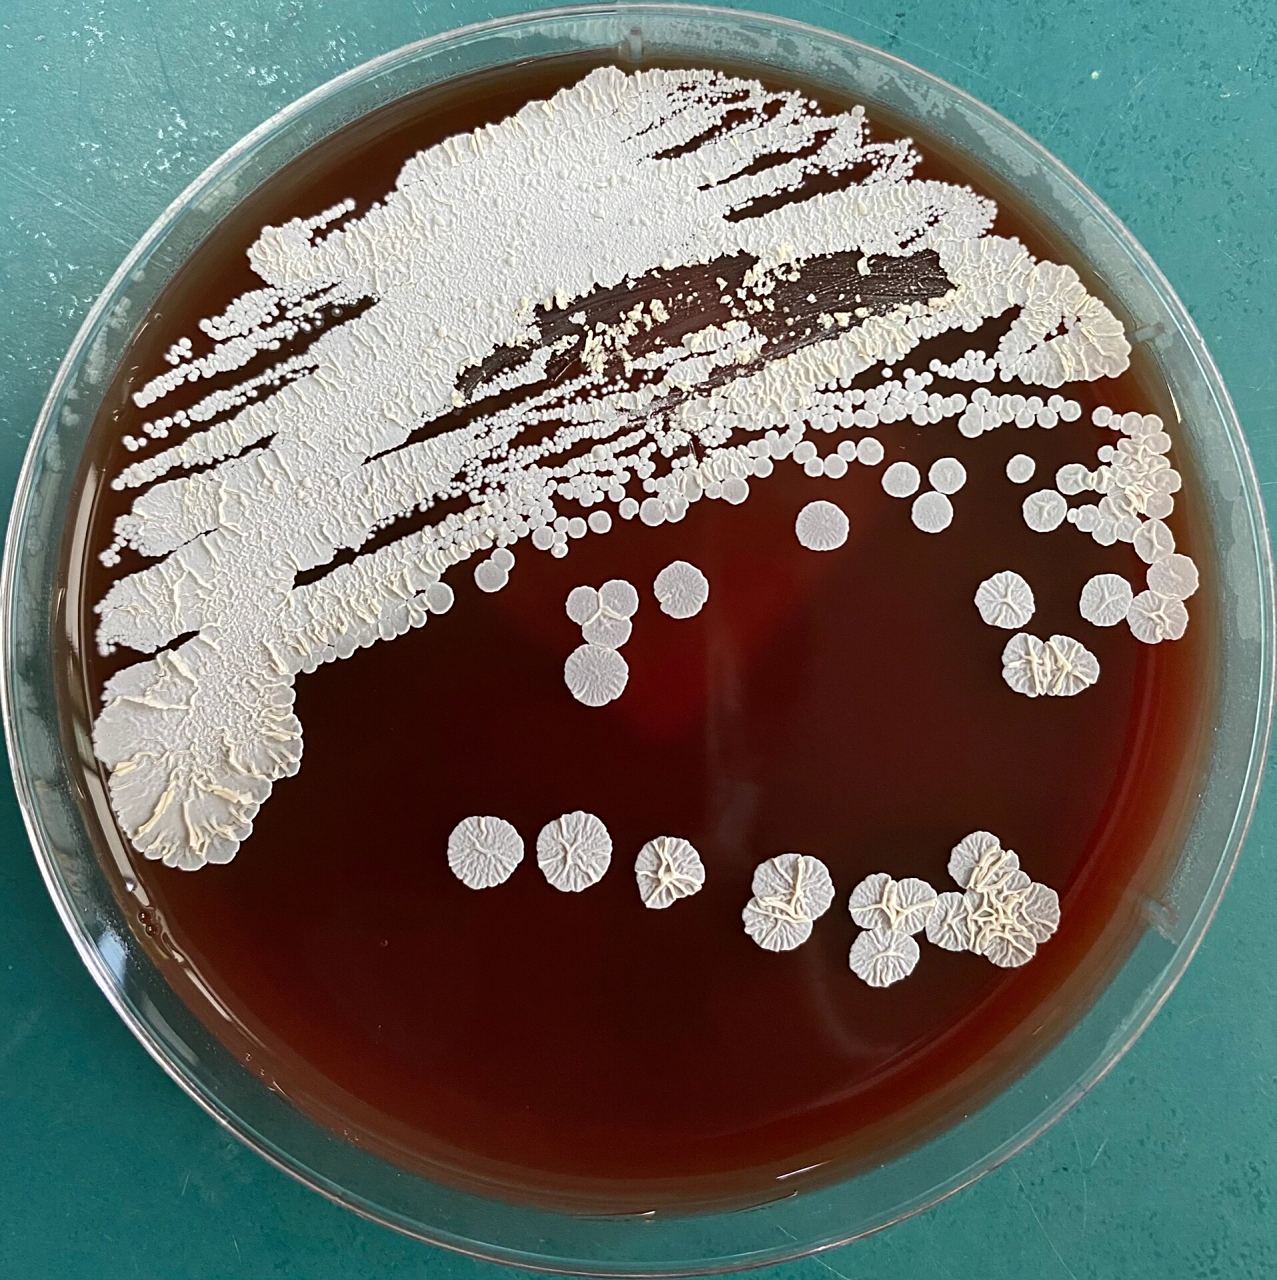
圣乔治教堂诺卡菌 balf培养,圣乔治教堂诺卡菌 p1,血平板菌落形态 p2
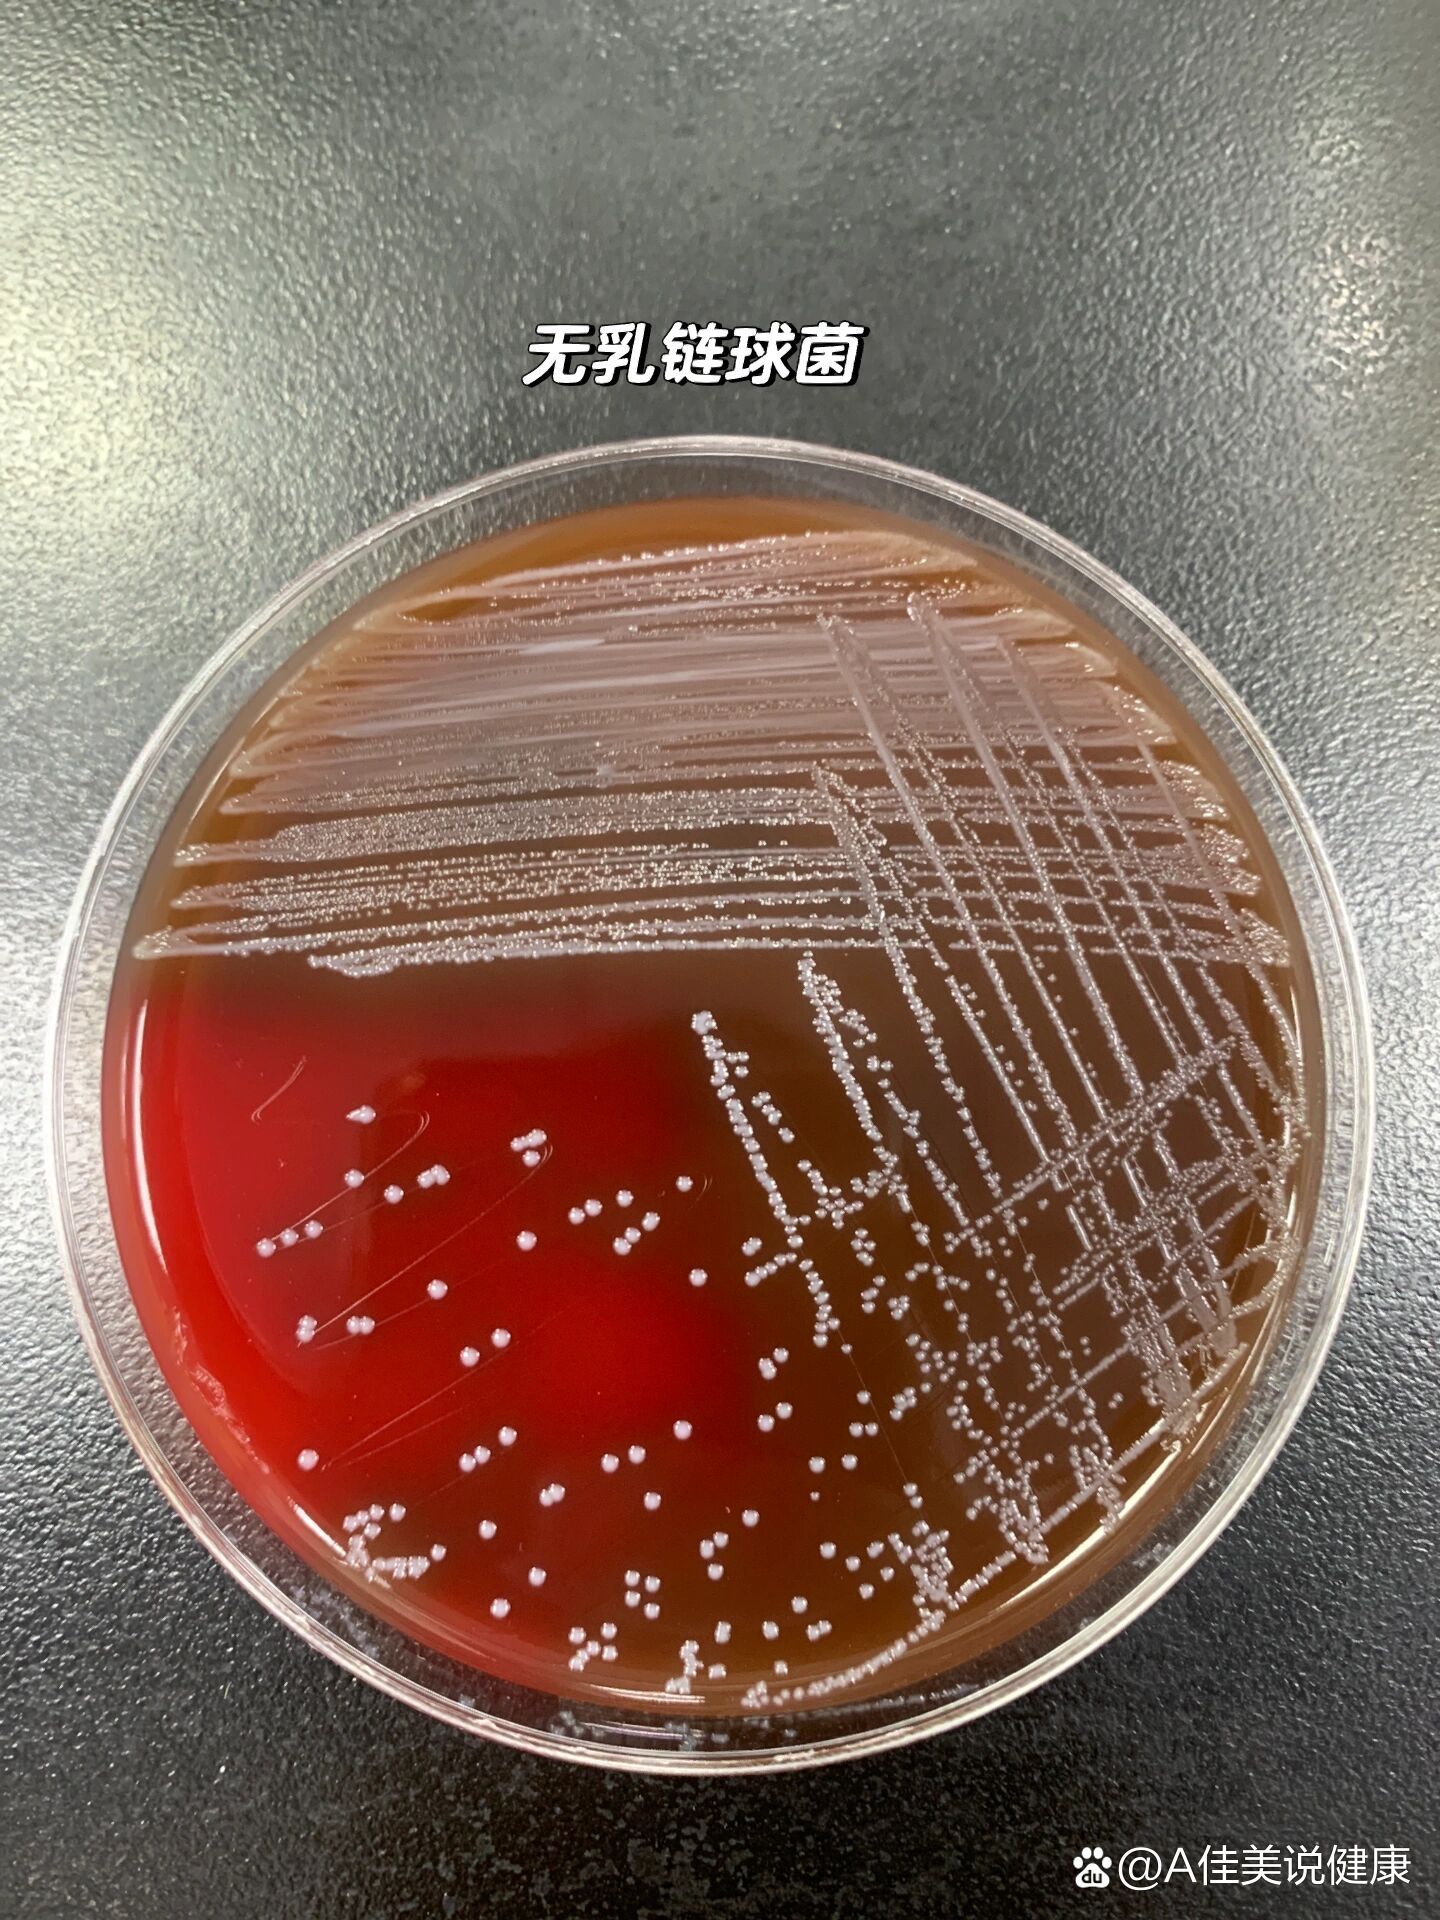
>新生儿脑脊液标本在血平板上培养24小时的呈草绿色溶血的无乳链球菌
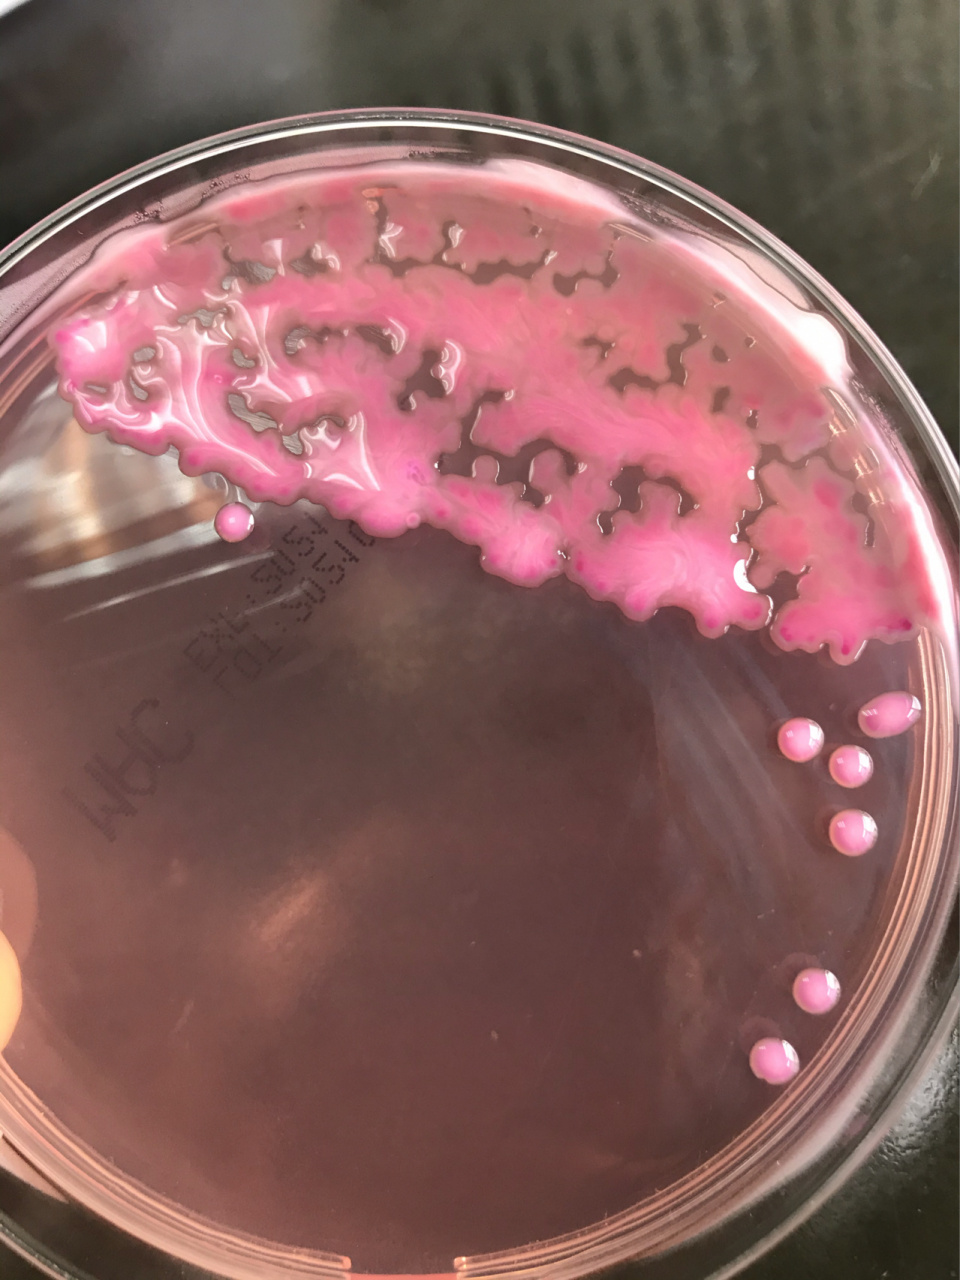
痰培养 基本上是一个肺炎克雷伯菌 血平板菌落不是常见菌落,像鼻涕一

血平板上各菌菌落形态

血平板上不同细菌菌落形态.#创作灵感 #微生物 #实验室 - 抖音
图片尺寸1920x1808
ss平板无色菌落,志贺菌,血清凝集试验:福氏志贺菌 - 抖音
图片尺寸1874x1764
ss平板无色菌落,志贺菌,血清凝集试验:福氏志贺菌 - 抖音
图片尺寸1832x1804
图1:tcbs平板上菌落形态 图23:血平板上菌落形态
图片尺寸960x1280
分纯的流感嗜血杆菌,巧克力琼脂平板上生长较佳:圆形,光滑,湿润,边缘
图片尺寸1280x960
五种致泻性大肠杆菌在ss平板上的菌落形态
图片尺寸960x1280
五种致泻性大肠杆菌在ss平板上的菌落形态
图片尺寸960x1280
金黄色葡萄球菌在血平板上菌落形态
图片尺寸1024x682
图8:血平板菌落形态6.
图片尺寸597x614
金黄色葡萄球菌血平板菌落特征
图片尺寸1200x1621
圣乔治教堂诺卡菌 balf培养,圣乔治教堂诺卡菌 p1,血平板菌落形态 p2
图片尺寸1277x1280
鲍曼不动杆菌的血平板
图片尺寸1080x1439
每天认识菌day1 图片为血平板表现 先猜猜是什么菌 革兰染色:阳性球菌
图片尺寸1440x1920
表皮葡萄球菌在血琼脂平板上的菌落特征
图片尺寸530x391
木糖氧化无色杆菌
图片尺寸1920x2560
脓肿分枝杆菌 肺泡灌洗液培养,血平板,巧克力平板和中国蓝平板均生长.
图片尺寸1896x1920
>新生儿脑脊液标本在血平板上培养24小时的呈草绿色溶血的无乳链球菌
图片尺寸1440x1920
四个血平板均有细菌生长,从形态上筛选有三种细菌生长(图5):①菌落大
图片尺寸660x712
无乳链球菌:革兰阳性球菌. 血平板形态:灰白色,表面光滑,有 - 抖音
图片尺寸1080x1069
痰培养 基本上是一个肺炎克雷伯菌 血平板菌落不是常见菌落,像鼻涕一
图片尺寸960x1280